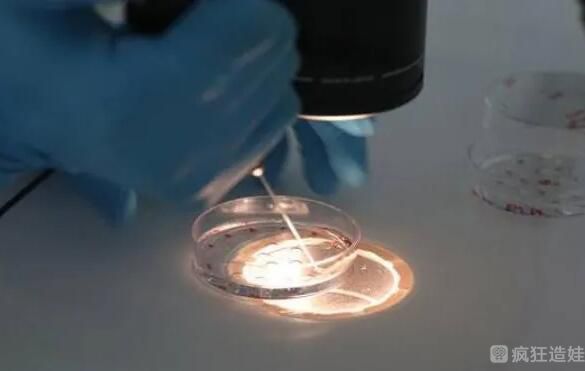

东莞市第三人民医院供卵第三代试管婴儿怎么样?附详细试管婴儿胚胎移植成功率?
- 试管婴儿
- 2024-06-16 09:30
东莞市第三人民医院供卵第三代试管婴儿怎么样?附详细试管婴儿胚胎移植成功率?东莞市第三人民医院(石龙人民医院),原名于慧医院,创建于1903年,已有百年辉煌历史。
医院位于东莞、广州、惠州三市交界处,是集医疗、教学、科研、保健为一体的市级综合性三级甲等公立医院,是东莞市松山湖地区的区域性医疗卫生中心。近年来,先后荣获全国医院管理创新先进单位、全国医院信息化先进单位、全国综合医院中医药示范单位、全国节约型公共机构示范单位、全国糖尿病健康教育管理认证单位、广东省卫生计生系统网站及新媒体建设评估优秀单位、广东省百家文明医院、广东省健康促进示范医院等称号。如今越来越严重,技术不负众望,帮助很多家庭生下了健康的宝宝。近年来,中国各个城市都设立了可以进行试管婴儿手术的医院。虽然技术参差不齐,但对于国内想做供卵第三代试管婴儿手术的家庭来说,是一件好事。
东莞市第三人民医院(石龙人民医院),原名于慧医院,位于东莞、广州、惠州三市交界处。是一所历史悠久,集医疗、教学、科研、保健为一体的市级三级公立综合医院。
东莞市第三人民医院生殖医学中心是东莞市较早获得卫生部批准的人类辅助生殖技术临床应用中心。集医、教、研于一体,拥有一批从事人类辅助生殖技术的专业专家。
这家医院在当地算得上是独一无二的医院,在东莞和广州也算是一家受关注的医院。它已经有100多年的历史了。在诊疗过程中,以试管婴儿患者为重点。是公立三级医院,也成为周边地区的特色诊疗单位。是当地的定点医保单位,可以给更多的患者带来良好的治疗效果。很多病人喜欢来这里就医。
如果在这里做供卵第三代试管婴儿手术,值得关注的是。举个简单的例子,试管婴儿的胚胎移植成功率并没有我们想象的那么低。虽然国内试管婴儿的胚胎移植成功率一般保持在30%左右,但基本上这家医院的胚胎移植成功率能达到50%左右。如果是更年轻的患者,他们的胚胎移植成功率甚至可以一次性达到。这里确实有很多年轻患者一次成功,所以要根据每个人的实际情况来决定。
试管婴儿的流程大致分为促排卵、取卵取精、胚胎培养、检测、移植,到了不同的阶段其操作步骤会有差异。由于试管婴儿本身的费用、流程、胚胎移植成功率无非是姐妹们最关心的几个问题,下面是这家医院胚胎移植成功率的数据:
1.25-35岁男女生殖功能良好,试管婴儿胚胎移植成功率约为50%-60%。
2.35-40岁女性和男性年龄大了,尤其是女性,卵巢可能会出现异常。试管婴儿胚胎移植成功率只有40%左右。
3.40-50岁女性和男性生育能力逐渐下降,这个阶段试管婴儿胚胎移植成功率只有20%-30%左右;
4.50岁以上的男女不再生育,都是超,有试管婴儿的不超过10%。
目前东莞市人民医院生殖医学中心的试管婴儿妊娠率为45-50%,IUI妊娠率为15%,与国内大型生殖医学中心相同。同时,该科还配备了完善的不孕不育检查项目,可以对不育和进行系统的诊断和治疗。可以根据患者的不同情况选择不同的治疗方案,只为提高患者的胚胎移植成功率。
无论是国内的第一代试管婴儿、第、第三代试管婴儿,都达到国家标准,都可以达到50%左右。但细节因人而异,每个患者的实际情况也必然不同。
以上就是关于东莞市第三人民医院供卵第三代试管婴儿怎么样?附详细试管婴儿胚胎移植成功率?的全部内容。如果还有疑惑的话欢迎咨询试管婴儿资讯分享平台的专业生殖顾问。

发表评论